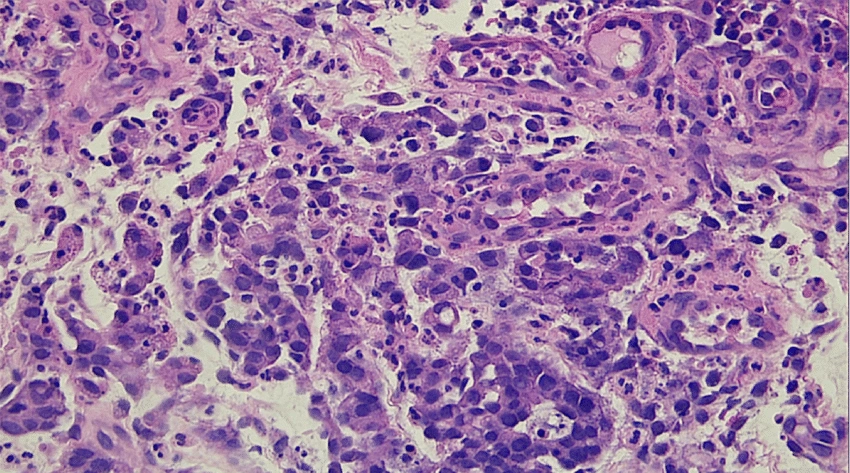

Рак желудка: симптомы, причины, виды, стадии, метастазы, диагностика, лечение и прогноз выживаемости при онкологии желудка

Рак желудка
Рак желудка – злокачественная опухоль, формирующаяся из клеток внутреннего слизистого слоя желудочной стенки. По мере увеличения она прорастает в средний мышечный и внешний серозный слои, соседние и отдаленные органы. Чаще возникает у мужчин. Средний возраст больных – 38 лет.
Смотрите также- Аденокарцинома желудка
- Перстневидноклеточный рак желудка
- Рак антрального отдела желудка
- Рак кардиального отдела желудка
- Лечение рака желудка
- Диагностика рака желудка
Рак желудка – злокачественная опухоль, формирующаяся из клеток внутреннего слизистого слоя желудочной стенки. По мере увеличения она прорастает в средний мышечный и внешний серозный слои, соседние и отдаленные органы. Чаще возникает у мужчин. Средний возраст больных – 38 лет.
Патология занимает 3 место в мире по уровню смертности от онкозаболеваний: ежегодно от нее умирает 800 000 человек. По статистике выздоравливают 30 % пациентов с раком желудка. Метастазы выявляют у 80-90 % больных. При ранней диагностике 6-месячная выживаемость – 65 %, при поздней – 15 %. На практике чаще выявляется на 4-й стадии. У 1 из 50 больных с диспепсией диагностируют рак желудка.

Причины и факторы риска рака желудка
На вероятность возникновения заболевания влияют:
- наличие близких родственников с раком желудка в анамнезе,
- полипы желудка или аденоматозный полипоз,
- язвенная болезнь и хронический гастрит,
- повышенный уровень Helicobacter Pilory,
- дуодено-гастральный рефлюкс,
- кишечная метаплазия – замещение желудочного эпителия кишечным,
- неправильное питание – большое количество соленой, острой и копченой пищи, животных жиров, низкое содержание овощей и фруктов,
- недостаток витамина С,
- употребление низкокачественных и просроченных продуктов,
- курение и избыточное потребление алкоголя,
- возраст старше 60 лет, особенно у мужчин,
- срок 5-10 лет после операции на желудке.
Наличие факторов риска не означает, что вы точно заболеете. Отсутствие факторов риска не означает, что вы точно не заболеете.
Основные симптомы онкологии желудка
Первые признаки заболевания – дискомфорт и боль в области желудка, диспепсия. Кроме них на ранних стадиях возникают Источник:
Бессимптомное течение рака желудка. Шут С.А., Платошкин Э.Н., Дорогокупец А.Ю.: Проблемы здоровья и экологии, 2019 г. :
- изжога,
- тошнота,
- снижение аппетита,
- ощущение вздутия после еды,
- дискомфорт в верней части живота,
- повышенная утомляемость, слабость.
На более поздних стадиях симптомы рака желудка:
- рвота,
- кал черного цвета,
- отрыжка,
- чувство переполненного желудка,
- боли в животе,
- желтуха,
- асцит – увеличение объема живота из-за скопления жидкости,
- потеря веса.
Без лечения возможны осложнения рака желудка – кровотечения, перфорация опухоли, желудочная непроходимость, флегмона.
Виды рака желудка
В большинстве случаев (более 90 %) рак желудка развивается в виде аденокарциномы. Это злокачественное поражение железистого эпителия. Аденокарцинома подразделяется на следующие виды:
- Тубулярная – состоит из тубулярных структур, находящихся в фиброзной строме. В просветах желез вырабатывается слизь, развиваются кистозные полости.
- Папиллярная (сосочковая) – новообразование представлено ворсинками с фиброзной основой.
- Муцинозая (слизистый рак). Более чем наполовину состоит из муцина – основного компонента секрета желудочных желез. Клетки расположены хаотично или выстроены в цепочку, вокруг которой имеется скопление слизи.
- Перстневидноклеточная. Более половины новообразования занимают клетки с муцином в цитоплазме. Он сдвигает ядро клетки в сторону, из-за чего она принимает перстневидную форму. В некоторых классификациях перстневидноклеточные опухоли относят к фиброзным, так как они имеют склонность к диффузной инфильтрации, однако функционально они часто имеют примесь железистого компонента и поэтому являются железистыми.
По степени дифференцировки аденокарцинома может быть высоко-, средне- или низкодифференцированной.
Гораздо реже диагностируются другие виды рака желудка. Среди них:
- Коллоидный (слизистый) рак. Новообразование, сформированное в виде пластов из клеток, содержащих слизь. Располагается чаще всего в подслизистом слое либо между слоями мышечной оболочки.
- Фиброзный рак (скирр, скиррозный). Содержит гипертрофированную соединительную ткань с содержанием, иногда – весьма незначительным, малигнизированных клеток в форме куба, которые образуют тяжи и ячейки.
- Солидный (мозговой) рак. Ткань опухоли анаплазирована, в ней определяется большое количество мелких злокачественных клеток полигональной формы. Соединительнотканная строма присутствует в минимальном количестве.
- Мелкоклеточный рак. На его долю приходится лишь около 0,6 % от всех видов рака желудка. Из мелких клеток, по форме напоминающих лимфоциты, формируются пласты или солидные структуры. Во многих клетках присутствуют нейроэндокринные гранулы.
- Плоскоклеточный рак. Развивается очень редко. Опухоль происходит из метаплазированного железистого эпителия. Может быть поверхностным – поражение наружных слоев слизистой оболочки, и инвазивным – проникает в глубокие слои органа.
- Смешанные формы.
Отдельно можно выделить недифференцированный рак, когда невозможно определить происхождение клеток опухоли. Он развивается в эпителиальных тканях, быстро достигает значительного размера, располагается в проксимальном отделе желудка или заполняет его полностью. Эпителий при этой форме рака деформируется, приобретает рыхлую и пористую структуру.
Аденокарцинома желудка (гистология)
Стадии рака желудка
По степени злокачественности и распространенности процесса различают стадии заболевания:
- 0 – единичные атипичные клетки обнаруживают только в верхнем слое слизистой желудка,
- I – клетки опухоли поражают слизистый и подслизистый слои желудочной стенки.

Эндоскопические признаки раннего рака желудка поверхностного депрессивного (0 IIc) типа в теле желудка
I стадия делится на подстадии:
- I А – поражен только подслизистый слой,
- I В – поражен также мышечный слой желудка, выявлены метастазы в 1-2 близлежащих лимфоузлах.
II стадия делится на подстадии:
- II A – опухоль распространяется:
- на подслизистый или мышечный слои желудочной стенки, в 1-2 близлежащих лимфоузлах выявлены метастазы,
- подслизистый слой с метастазами в 3-6 близлежащих лимфоузлах.
- на внешний слой желудочной стенки,
- субсерозный слой ткани под внешней оболочкой с метастазами в 1-2 близлежащих лимфоузлах,
- мышечный слой желудочной стенки с метастазами в 3-6 близлежащих лимфоузлах,
- подслизистый слой желудочной стенки с метастазами в 7 или более близлежащих лимфоузлах.
III стадия делится на подстадии:
- III A – опухоль распространяется:
- на внешний слой желудочной стенки с метастазами в1-2 близлежащих лимфоузлах,
- серозный слой ткани под внешней оболочкой с метастазами в 3-6 близлежащих лимфоузлах,
- мышечный слой желудочной стенки с метастазами в 7 или более близлежащих лимфоузлах.
- в близлежащие органы – селезенку, печень, диафрагму, почку, надпочечник, поджелудочную железу, поперечно-ободочную или тонкую кишку с метастазами в 1-2 близлежащих лимфоузла,
- во внешний слой желудочной стенки с метастазамив 3-6 близлежащих лимфоузлах.
- в близлежащие органы – селезенку, печень, диафрагму, почку, надпочечник, поджелудочную железу, поперечно-ободочную или тонкую кишку с метастазами в 3 и более лимфоузла,
- во внешний слой желудочной стенки с метастазами в 7 и более близлежащих лимфоузла.
IV стадия – опухоль за счет метастазирования распространяется в отдаленные органы и ткани – печень, яичники, надключичные лимфоузлы и т.п.
Метастазы при раке желудка
Существуют имплантационный, лимфогенный и гематогенный пути метастазирования рака желудка.
При имплантационном пути метастазирования злокачественный процесс разрушает капсулу органа, и раковые клетки обсеменяют ту или иную полость организма. Такие метастазы рака желудка часто представлены канцероматозом брюшины, сальника, диафрагмы, перикарда, плевры.
При лимфогенном пути метастазы рака желудка выявляются в регионарных лимфоузлах 1-го и 2-го этапа лимфооттока – располагающихся по ходу желудочных и желудочно-сальниковых артерий, селезеночной артерии, и в более отдаленных л/узлах.
Выделяют специфические для рака желудка лимфогенные метастазы:
- Вирхова, или Вирховские узлы – в л/узлы слева над ключицей, между ножками грудино-ключично-сосцевидной мышцы,
- Шницлера – в лимфатические узлы параректальной зоны,
- Айриша – поражение подмышечных лимфоузлов,
- сестры Марии Джозеф (встречается редко) – в пупок по ходу круглой связки печени,
- Крукенберга – в яичники.
Метастазы в лимфоузлах – одна из главных причин неудовлетворительных результатов оперативного лечения рака желудка. Злокачественный процесс редко диагностируется на ранних стадиях, в 64,2 % случаев его обнаруживают на III-IV ст., при этом у 83 % таких пациентов уже имеются метастазы в регионарных лимфоузлах. Кроме того, лимфогенные метастазы находят у 70 % пациентов, оперированных по поводу рака желудка. Чаще выявляется поражение от 2 до 5 узлов. Особенностью метастазирования при этом типе рака являются «прыгающие» метастазы – поражающие узлы 2-го этапа лимфооттока, не затрагивая при этом лимфоузлы 1-го этапа. Частота лимфогенного метастазирования напрямую связана с глубиной проникновения злокачественного новообразования в стенку желудка.
При гематогенном пути метастазирования чаще всего поражается печень, куда раковые клетки попадают с током крови по воротной вене. Не исключены метастазы рака желудка в легкие, мозг, почки, кости. Реже встречается метастазирование в поджелудочную железу и надпочечники.
Диагностика онкологии желудка
Чтобы поставить диагноз, проводят эндоскопическое исследование желудка ЭГДС. Через рот и пищевод вводят зонд с миниатюрной видеокамерой и источником света. Процедура позволяет выявлять местоположение опухоли. В ходе ее выполнения также делают биопсию – забор образца тканей для гистологического анализа. Диагноз подтверждают только после исследования тканей опухоли под микроскопом.

Для определения точных размеров новообразования проводят КТ, иногда – с контрастным усилением. Для оценки распространенности процессов, состояния лимфоузлов и выявления метастазов назначают УЗИ. Для уточнения специфических характеристик опухоли делают рентгенографию с препаратами бария.
Уточняющая диагностика помогает выбирать наиболее эффективную лечебную тактику. Так, исследование крови на мутацию гена HER2/neu помогает подобрать наиболее эффективные противоопухолевые препараты. Кроме этого, назначают:
- анализы на онкомаркеры РЭА и СА-19,9,
- внутрижелудочное УЗИ,
- позитронно-эмиссионную томографию (ПЭТ).

Умеренно дифференцированная аденокарцинома желудка с подслизистой инвазией
Методы лечения рака желудка
Основной метод лечения рака желудка – хирургический. Лучевую и химиотерапию проводят дополнительно для повышения эффективности лечения Источник:
Комбинированное лечение рака желудка. Афанасьев С.Г., Тузиков С.А., Давыдов И.М.: Сибирский онкологический журнал, 2015 г. . В качестве монометодик при раке желудка они малоэффективны и назначаются, если операция противопоказана.Хирургическое лечение
Хирургическое лечение проводят на всех стадиях рака желудка: на ранних для радикального удаления опухоли и полного восстановления пациента, на поздних –чтобы улучшить качество жизни больного и уменьшать выраженность симптоматики.Объем операции зависит от злокачественности и распространенности новообразования, возраста и состояния здоровья пациента Источник:
Хирургическое лечение рака желудка. Рахов С.Б.:Вестник Казахского Национального медицинского университета, 2012 г. .Гастрэктомия – удаление всего желудка с опухолью, окружающей жировой клетчаткой и регионарными лимфоузлами. В ходе вмешательство возможна частичная либо полная резекция пораженных соседних органов. После иссечения формируют искусственное соустье – аностомоз – между пищеводом и тонким кишечником.
Резекция желудка дистальная либо проксимальная – удаление пораженной верхней либо нижней части с клетчаткой и регионарными лимфоузлами.
Эндоскопическая резекция желудочной слизистой – удаление пораженного участка слизистой через проколы без разрезов. Эффективна на начальной стадии онкопроцесса, а также у пожилых и ослабленных больных, которым из-за состояния противопоказана полноценная операция.
Химиотерапия
Лечение с помощью лекарственных препаратов, разрушающих раковые клетки либо блокирующих их деление. Введение одновременно нескольких таких медикаментов – полихимиотерапия – позволяет снизить дозировки каждого их них и негативные побочные эффекты лечения, повысить его эффективность. Назначается перед хирургической операцией либо после нее.

Макроскопические данные эндоскопии верхних отделов желудочно-кишечного тракта. (a) В передней стенке тела желудка выявлена опухоль 3-го типа размером 95*75 мм в диаметре. (b) После трех курсов химиотерапии наблюдалось заметное уменьшение размеров опухоли.
Лучевая терапия
Использование рентгеновских лучей для разрушения клеток опухоли или замедления ее роста. Показано до или после операции, при метастазах в лимфоузлах, на поздних стадиях и при невозможности хирургического лечения. Для точной фокусировки (чтобы убивать опухоль, не воздействуя на близлежащие ткани)используют КТ-разметку.
Прогнозы при раке желудка
Прогноз зависит от стадии онкопроцесса – насколько обширно и глубоко поражена желудочная стенка, поражены ли лимфоузлы и есть ли метастазы, а также от возраста и общего состояния здоровья пациента. При ранней диагностике и качественном лечении шанс на полное выздоровление значительно выше.
- у пациентов с 1-й стадией – 80%, из них 70% полностью выздоравливают,
- у больных со 2-й стадией – 56%, из них полностью выздоравливает 50 %,
- у пациентов с 3-й стадией – 38%, из них полностью выздоравливает 25 %,
- у больных с 4-й стадией – 5%, из них полностью выздоравливают 1,4 %.
Если пациент прожил 5 лет после окончания лечения рака желудка, дальнейший прогноз улучшается. Риск рецидива зависит от стадии и обширности метастаз. Он выше через 2 года и снижается после 5-летней ремиссии.
Профилактика заболевания
- Сбалансированный рацион с преобладанием фруктов и овощей.
- Отказ от курения и злоупотребления алкоголем.
- Современное лечение болезней желудка – в частности HelicobacterPilory – с последующим врачебным наблюдением.
Важны также регулярные профилактические осмотры и скриниг людей с генетической и наследственной предрасположенностью к заболеванию.
Источники:
- Бессимптомное течение рака желудка. Шут.С.А., Платошкин Э.Н., Дорогокупец А.Ю.: Проблемы здоровья и экологии, 2019 г.
- Комбинированное лечение рака желудка. Афанасьев С.Г., Тузиков С.А., Давыдов И.М.: Сибирский онкологический журнал, 2015 г.
- Хирургическое лечение рака желудка. Рахов С.Б.:Вестник Казахского Национального медицинского университета, 2012 г.
- Иммунотерапия рака желудка. Мансорунов Д.Ж., Алимов А.А., Апанович Н.В., Кузеванова А.Ю., Богуш Т.А., Стилиди И.С., Карпухин А.В.: Российский биотерапевтический журнал, 2019 г.
Информация в статье предоставлена в справочных целях и не заменяет консультации квалифицированного специалиста. Не занимайтесь самолечением! При первых признаках заболевания необходимо обратиться к врачу.
"